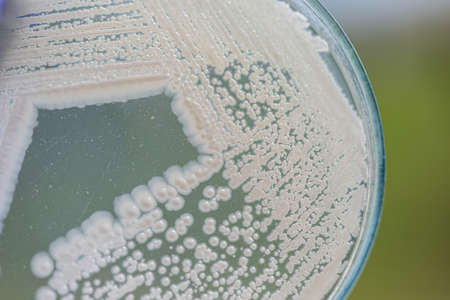
Yeast in petri dish, Microbiology for education in laboratories.の写真素材

写真素材 - Yeast in petri dish, Microbiology for education in laboratories.
キーワード
- agar
- analysis
- background
- bacteria
- bacterial
- bacteriology
- bacterium
- bakers
- biochemistry
- biology
- biotechnology
- budding
- cell
- cells
- colony
- culture
- cytoplasm
- disease
- dish
- education
- eukaryotic
- examination
- experiment
- fungi
- growing
- growth
- health
- isolated
- lab
- laboratories
- laboratory
- medical
- medicine
- micro-organisms
- microbiological
- microbiologist
- microbiology
- microscope
- plate
- pseudomonas
- research
- safety
- science
- structures
- study
- technology
- test
- wall
- white
- yeast
類似作品
Science and Lif...
Backgrounds of ...
macro of bacter...
Backgrounds of ...
Colony of bacte...
Backgrounds of ...
bacteria colony...
Backgrounds of ...
petri dish with...
Backgrounds of ...
close-up of col...
Colonies of bac...
Bacterial T-str...
Backgrounds of ...
Science and Lif...
red colony in p...
microbial cultu...
Backgrounds of ...
macro of fungi ...
Colonies of dif...
petri dish fill...
blood sample in...
Petri dish with...
Backgrounds of ...
Bacterial cultu...
bacteria colony...
Macro close up ...
Close up of bac...
Close-up detail...
bacteria colony...
development and...
3d rendering of...
Colony of bacte...
Plant Petri on ...
Glass pipette a...
Background from...
Colorful microb...
Bacteria growin...
petri dish with...
Colonies of bac...
Laboratory tech...
Microbiology.
Bacterial colon...
bacteria colony...
Exploring vibra...
Backgrounds of ...
Colonies of bac...
Green mold grow...
This image show...